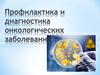
Профилактика и диагностика онкологических заболеваний

Similar presentations:
Питание, БАД и профилактика онкологических заболеваний
1.
Питание, БАД ипрофилактика
онкологических
заболеваний
Лысиков
Юрий Александрович
Вебинар. 22.05.14.
2.
Что такое онкология?2
ОНКОЛОГИЧЕСКИЕ заболевания – «достаточно
широкая группа заболеваний», которые отличаются
этиологией (причиной) и патогенезом (течением
заболевания)
«онкос» - опухоль = новообразование:
ДОБРОКАЧЕСТВЕННАЯ – локальный, медленный рост
ЗЛОКАЧЕСТВЕННАЯ – проникающий, быстрый рост
Типичные клетки – аденома, фиброма, миома
Атипичные клетки – недифференцированные опухоли
Особенностью онкологических заболеваний является
НЕКОНТРОЛИРУЕМЫЙ и БЫСТРЫЙ рост клеток
ОНКОЛОГИЧЕСКИЕ ЗАБОЛЕВАНИЯ могут быть
вызваны вирусами, бактериями, простейшими
паразитами, канцерогенными веществами,
мутагенами, а также развиваться при сбое и
нарушении процессов ПРОЛИФЕРАЦИИ и АПОПТОЗА
3.
ОНКОЛОГИЯ – факторы риска• ВИРУСЫ – например, вирус папилломы человека
3
• КАНЦЕРОГЕНЫ – например, бензпирен, кобальт, свинец,
продукты окисления насыщенных жиров
• ТОКСИЧЕСКИЕ ВЕЩЕСТВА – МУТАГЕНЫ
• ЛЕКАРСТВЕННЫЕ ПРЕПАРАТЫ – канцерогены и мутагены
• СТИМУЛЯЦИЯ ПРОЛИФЕРАТИВНОЙ АКТИВНОСТИ – риск
нарушения пролиферации и неконтролируемого клеточного роста
(чрезмерная нагрузка на желудок, печень)
• НАРУШЕНИЕ АПОПТОЗА (программируемой гибели клеток) – риск
неконтролируемого клеточного роста
• ВОЗРАСТ – сбои и снижение активности иммунной системы и
систем контроля в организме
• ГОРМОНОЗАВИСИМЫЕ ОПУХОЛИ (эстрогены) – рак молочной
железы, матки, предстатальной железы
• ИММУНОДЕФИЦИТ – нарушение иммунного контроля и
уничтожение атипичных и раковых клеток
• ФАКТОРЫ ПИТАНИЯ – нарушение процессов регуляции
обмена веществ и физиологических процессов в организме,
поступление в организм канцерогенных и мутагенных веществ
4.
Стратегия профилактики онкологии• ЗАЩИТА от ВИРУСНОЙ ИНФЕКЦИИ – профилактика,
вакцинация, терапия
• ЗАЩИТА от КАНЦЕРОГЕННЫХ ФАКТОРОВ ВНЕШНЕЙ
СРЕДЫ – избегание + техника безопасности
• КОНТРОЛЬ и СТИМУЛЯЦИЯ ИММУННЫХ МЕХАНИЗМОВ
КОНТРОЛЯ – цитотоксической и киллерной активности
• УМЕНЬШЕНИЕ НЕОБОСНОВАННОГО ПРИЕМА
ЛЕКАРСТВЕННЫХ ПРЕПАРАТОВ – мутагенов
• ДЕТОКСИКАЦИИ ОРГАНИЗМА – очистка и выведение из
организма и ЖКТ токсических веществ
• МЕТАБОЛИЧЕСКАЯ ПОДДЕРЖКА СИСТЕМ
ДЕТОКСИКАЦИИ ( ЖКТ, ПЕЧЕНЬ, ПОЧКИ) – ускоение
выведения токсических и канцерогенных веществ из
организма
• ПОДДЕРЖКА НОРМАЛЬНОГО МИКРОБИОЦЕНОЗА
КИШЕЧНИКА, участвующего в защите организма
• ФАКТОРЫ ПИТАНИЯ
от 10 до 70%
– их вклад оценивают
4
5.
Стратегия ПИТАНИЯ в профилактикеонкологии 5
• УМЕРЕННОЕ ПИТАНИЕ – снижает обмен веществ, замедляет старение и
инволюцию органов и систем организма , уменьшает проникновение в организм
токсических и канцерогенных веществ, облегчает детоксикацию и выведение
вешеств из организма
• УПОТРЕБЛЕНИЕ ПРОСТОЙ, ЧИСТОЙ и ЭКОЛОГИЧЕСКИ
БЕЗОПАСНОЙ ПИЩИ и ВОДЫ – канцерогенные и токсические факторы
в составе пищи и воды)
• СНИЖЕНИЕ УПОТРЕБЛЕНИЯ ЖАРЕННЫХ и КОПЧЕНЫХ
ПРОДУКТОВ, содержащих канцерогенные вещества
• УВЕЛИЧЕНИЕ ПОТРЕБЛЕНИЯ ПИЩЕВЫХ ВОЛОКОН –
детоксикация организма, питательная поддержка микрофлоры кишечника
• ПИТАТЕЛЬНАЯ ПОДДЕРЖКА МИКРОБИОЦЕНОЗА
КИШЕЧНИКА - потребление ПРЕБИОТИКОВ
• МЕТАБОЛИЧЕСКАЯ ПОДДЕРЖКА ВСЕХ СИСТЕМ
ОРГАНИЗМА – увеличение потребления ВИТАМИНОВ и БИОЭЛЕМЕНТОВ
• СНИЖЕНИЕ ОБРАЗОВАНИЯ ПЕРЕКИСЕЙ ЛИПИДОВ и
РАДИКАЛОВ КИСЛОРОДА – увеличение потребления АНТИОКСИДАНТОВ
• БЕЗОПАСНЫЙ РЕЖИМ КУЛИНАРНОЙ ОБРАБОТКИ ПИЩИ
6.
Факторы питания – снижение рискаонкологии 6
Снижение потребления ЖИВОТНОГО БЕЛКА
Снижение потребления МЯСНЫХ ПРОДУКТОВ
Снижение потребления ЖИВОТНОГО ЖИРА
Снижение КАЛОРИЙНОСТИ питания
Недопущение переедания в ДЕТСКОМ возрасте
Сохранение необходимого потребления ХОЛЕСТЕРИНА
Регулярное употребление ОВОЩЕЙ – источника
ПИЩЕВЫХ ВОЛОКОН (до 30-40 г/день) – «Локло»
• Регулярное употребление рыбы – источника ω-3 ПНЖК –
«Омега-3 ПНЖК» (300 мг)
• Прием ВИТАМИНА С – «Супер Комплекс», «Витамин С»
• Прием в-Каротина – «Лив Гард» (6,8 мг/136%), «Замброза» (
2,54 мг/51%), «Супер Комплекс» (1,95 мг/39%)
• Увеличение содержания КАЛЬЦИЯ – «Кальций Магний
Хелат» (250 мг/25%), «Коралловый кальций» (360 мг/36%)
• Регулярный прием ВИТАМИНОВ – «Супер Комплекс»,
«ТНТ»
7.
Факторы питания: что известно?7
• Потребление 450 г фруктов и овощей в день – снижает риск
онкологии на 45% в сравнении с 285 г
• Потребление более 60 г этанола (144 мл водки) в день
увеличивает риск онкологии в 50 раз
• Избыточная МТ – повышает риск онкологии
• Физическая активность (30 мин/день) – снижает риск онкологии и
важна в период реабилитации (Конф.Всемирного Фонда Раковых исследований, 2000)
Действие Омега-3 ПНЖК (Fearon K.C.H., 2002):
• снижение токсичности противоопухолевых лекарств
• лечение онкологической кахексии
• снижение роста опухоли на 31% в эксперименте – активация CD8 –
лимфоцитов (Robinson L.E. et al., 2001)
Снижение риска онкологии при увеличении потребления: Калия,
каротиноидов, в-каротина, в-криптоксантина, ликопина, лютеина,
витаминов С, Е, В6 (Levi F. et al, 2001)
Сульфорафан (брокколи) индуцирует ферменты, связывающие
канцерогены (Lin H. et al., 2001)
изотиоционаты (свежая брокколи) – активируют ферменты детоксикации и
репарации ДНК- профилактика рака легких, желудка и толстой кишки
Полифенолы зеленого чая (катехины) – ингибируют пролиферацию
гладкомышечных клеток сосудов
Флавоноиды – антипролиферативная активность
8.
Профилактика ракаполости рта, пищевода и желудка
8
ФАКТОРЫ РИСКА:
• Употребление КРЕПКИХ АЛКОГОЛЬНЫХ напитков
• Использование ГОРЯЧЕЙ ПИЩИ
• Употребление КОПЧЕНОЙ и МАРИНОВАННОЙ пищи –
содержат КАНЦЕРОГЕННЫЕ вещества
• Высокое содержание в пище НИТРАТОВ
• Дефицит в питании ОВОЩЕЙ и ФРУКТОВ
• Дефицит в питании ВИТАМИНОВ (А, С, Рибофлавина,
Ниацина) и БИОЭЛЕМЕНТОВ (Кальция, Mагния, Цинка, Селена,
Молибдена) – «Суперкомплекс», «ТНТ»
ФАКТОРЫ ЗАЩИТЫ:
• ЗЕЛЕНЫЙ ЧАЙ - катехины
• Защитное действие КАПУСТЫ, ШПИНАТА – «Индол-3-карбинол»
• СОЕВЫЕ продукты – фитостерины
• Сырые ОВОЩИ, ЦИТРУСОВЫЕ, ОЛИВКОВОЕ масло – снижает риск
рака пищевода (Bozetti C., et al., 2000)
9.
Профилактика ракатонкой и толстой кишки
9
ФАКТОРЫ РИСКА:
• Низкое потребление ОВОЩЕЙ и ФРУКТОВ
• Недостаток в питании ВИТАМИНА С и КАРОТИНОИДОВ –
«Витамин С НСП» (1000 мг), «Лив Гард» (6,8 мг/136%), «Замброза» ( 2,54
мг/51%), «Супер Комплекс» (1,95 мг/39%)
• Недостаток КАЛЬЦИЯ – «Кальций Магний Хелат» (250 мг/25%),
«Коралловый кальций» (360 мг/36%)
• Употребление АЛКОГОЛЯ, особенно ПИВА
• Избыток ЖЕЛЕЗА
ФАКТОРЫ ЗАЩИТЫ:
ВЕГЕТАРИАНСКИЙ тип питания
Увеличение потребления МОЛОКА и молочных продуктов
Употребление ЧАЯ и КОФЕ – КАВЕОЛ и КАФЕСТОЛ, САЛИЦИЛАТЫ
ФОЛИЕВАЯ КИСЛОТА – «Супер Комплекс» (200 мг), «ТНТ» (200 мг),
«Солстик Нутришн» (200 мг)
• Изотиоционаты (свежая брокколи) – активируют ферменты
детоксикации и репарации ДНК- профилактика рака толстой кишки
10.
Профилактика ракаМолочной железы и матки
10
ФАКТОРЫ РИСКА:
• Излишняя КАЛОРИЙНОСТЬ питания
• Избыток БЕЛКА в питании
• Избыток в пище ЛИНОЛЕВОЙ КИСЛОТЫ (Омега-6)
• Употребление АЛКОГОЛЯ / КУРЕНИЕ
• Избыточное питание ДЕВОЧЕК в ДЕТСТВЕ – риск РАКА
ЯИЧНИКОВ
• Увеличенная МАССА ТЕЛА, ОЖИРЕНИЕ (Vasiljevich N., et al.,1998)
ФАКТОРЫ ЗАЩИТЫ:
• Высокий уровень витамина С – цитотоксичность по отношению к клеткам
рака молочной железы
•Защитное действие КАПУСТЫ и др. КРЕСТОЦВЕТНЫХ «Индол-3-карбинол»
• Употребление ОЛИВКОВОГО МАСЛА – МНЖК
• Ограничение приема ПИЩИ (полное голодание повышает чувствительность
к канцерогенам)
• Употребление СОЕВЫХ и других продуктов – источников фитоэстрогенов
• Употребление ВИТАМИНА Е, КАРОТИНОИДОВ и СЕЛЕНА - «Витамин Е» (400
мг), «Суперкомплекс»,
11.
Профилактике рака легких11
ФАКТОРЫ РИСКА:
• КУРЕНИЕ, которое усугубляется приемом КАРОТИНОИДОВ
• Недостаток ВИТАМИНА А и СЕЛЕНА
• Избыток ЖИРА в питании
• Низкое потребление ОВОЩЕЙ и ФРУКТОВ
• Изотиоционаты (свежая брокколи) – активируют ферменты детоксикации
и репарации ДНК- профилактика рака легких
Профилактика рака предстательной железы
• животный жир, красное мясо, алкоголь – увеличивают риск
• ликопин, в-каротин, витамины С, А и Е, кальций, селен, цинк,
пищевые волокна – снижают риск
• снижают риск смерти – овощи, изофлавоны
• ИПФР (мясо) и инсулин (углеводы) – увеличивают риск смертности
Профилактика рака эндометрия
Снижают риск:
• Употребление белка, фитостеролов, витамина С, фолатов,
каротиноидов, пищевых волокон, зерна, свежих овощей
(McCann S.T. et al.,2000)
• Уменьшение потребления насыщенных жиров, животных
жиров, снижение МТ (Jain M.G. et al.,2000)
12.
Онкопрофилактика: от А до Я6
1. ГЛЮКАРАТ КАЛЬЦИЯ (кальциевая соль глюкаровой кислоты).
содержится в яблоках, грейпфруте, вишне, абрикосах, брокколи,
брюссельской капусте. Участвует в процессе глюкуронизации
ксенобиотиков – связывании и выведении из организма
ксенобиотиков, обладающие канцерогенной активностью. Более чем
на 60%, снижает заболеваемость раком легких, кожи, груди и
толстой кишки, предотвращает индукцию рака простаты. «Брест
комплекс» (75 мг)
2. ГРИФОЛА КУРЧАВАЯ или МЭЙТАКЕ (Grifola frondosa) Содержит
полисахариды (р-1,6-гликаны), которые обладают
иммуностимулирующим действием. «Колострум НСП» (20 мг) /
«Брест комплекс» (4 мг)
3. ЛИКОПИН – каротиноид, обладает онкопротекторным действием в
отношении рака простаты, молочной железы, эндометрия, легких.
«Антиоксидант» (1,4 мг / 28%)
4. ПЕТРУШКА ПОСЕВНАЯ (Petroselinum crispum). Миристицин
снижает риск онкологии. «Перец, Чеснок, Петрушка»(125 мг) / «Про
Формула» (50 мг) / «Уро Лакс» (35 мг) / «Остео Плюс» (7,5 мг)
13.
Онкопрофилактика: от А до Я7
5. ИНДОЛ-3-КАРБИНОЛ – содержится в крестоцветных:
1. Приводит к торможению развития вируса папилломы человека
(ВПЧ) и приостанавливает формирование папилломатозных
образований, склонных к малигнизации: молочная железа,
аногенитальная область (переанальная область, вульва, вагина, шейка
матки), гортани и бронхов.
2. Дает хорошие результаты в профилактике рака шейки матки,
распространение которого у женщин приобретает характер эпидемии.
Его можно использовать при фиброзно-кистозной мастопатии и при
рецидивирующем папилломатозе гортани у детей.
3. Ускоряет метаболизм ксенобиотиков-канцерогенов в системе
цитохрома Р-450 клеток печени. «Индол-3-Карбинол» (136,6 мг /
273%) / «Грэпайн с Протекторами» (15 мг / 31%) / «Чеснок» (0,8 мг /
1,6%)
6. СОСНА ПРИМОРСКАЯ (Pinus maritima). Пикногенол оказывает
антимутагенное действие, защищают кожу от повреждающего
воздействия ультрафиолетового облучения. «Грэпайн с
Протекторами» (1 мг)
14.
Онкопрофилактика: от А до Я10
7. ТОКОТРИЕНОЛЫ – изомеры витамина E. Оказывают
онкопротективное действие. «Антиоксидант» (5 мг / 33%)
8. ТОМАТ (Solanum lycopersicum). Употребление томатов снижает риск
онкологических заболеваний: желудка, матки, поджелудочной железы,
простаты, молочных желез и ротовой полости. У мужчин, потребляющих
ежедневно томатный сок или соус, снижают риск заболевания раком
простаты на 50%. «Грэпайн с Протекторами» (20 мг) / «Чеснок»,
«Локло», «Супер Комплекс» – (5 мг), «ТНТ» (4 мг)
9. ХЛОРОФИЛЛ – зеленый пигмент:
1. В 1979 году экспериментально подтвердили предотвращение
возникновения опухоли толстой кишки.
2. Способен предотвращать нарушение структуры ДНК.
3. Блокирует первый этап превращения здоровых клеток в раковые,
являясь антимутагеном. Антимутагенными свойствами обладают все
растения, богатые хлорофиллом – брюссельская капуста, брокколи,
шпинат, люцерна, спирулина, ростки пшеницы. «Хлорофилл
жидкий» (14,9 мг) / «По Д’Арко НСП» (5 мг)
15.
Стимуляция активности клеток - киллеров17
1. АРАБИНОГАЛАКТАН – растворимый растительный полисахарид, часто
встречающийся в растениях, грибах и бактериях. Стимулирует активность
естественных клеток-киллеров и макрофагов. «Физ Актив» (100 мг /1%)
2. АСТРАГАЛ ПЕРЕПОНЧАТЫЙ (Astragalus membranaceus). Стимулирует
функцию NK-клеток и выработку интерферона. «Кошачий коготь НСП» (121
мг) / «Колострум НСП» (80 мг) / «Защитная Формула НСП» (16,6 мг) / «По
Д’Арко НСП» (5 мг)
3. БЕТА-ГЛЮКАНЫ – полисахариды. Активируют Т-лимфоциты, обладают
онкопротективным действием. «Физ Актив» (100 мг / 50%)
4. ГРИБ ШИИТАКЕ (Lentinula edodes). Лентинан поддерживает иммунитет у
онкологических больных, увеличивая скорость созревания лимфоцитовкиллеров и усиливая их активность. «Колострум НСП» (20 мг)
5. ГРИФОЛА КУРЧАВАЯ или МЭЙТАКЕ (Grifola frondosa) Стимулирует
активность Т-хелперов. «Колострум НСП» (20 мг) / «Брест комплекс» (4 мг)
6. КОРДИЦЕПС КИТАЙСКИЙ (Cordyceps sinensis). Стимулирует активность
Т-лимфоцитов, естественных киллеров (NK-клеток) и макрофагов, при этом
активность и действие NK-клеток увеличивается в 1,5 раза. «Кордицепс НСП»
(530 мг)
7. ТРУТОВЫЙ ГРИБ (Poria cocos) – нарост гриба на сосне. Полисахариды –
активируют макрофаги, выработку Т-хелперов, NK-клеток. «Буплерум Плюс»
(38,8 мг)
16.
Роль витаминов в онкопротекцииПрямая противоопухолевая активность: усиливают
действие клеток киллеров и цитотоксичность
Витамин С
Пиридоксин + цитотоксичность
Витамин А
Противовирусная защита клеток: увеличивают
выработку интерферона
Витамин С
Витамин В12
Фолиевая кислота
18
17.
Антиоксиданты-онкопротекторы NSP19
1. «АНТИОКСИДАНТ»:
ТОКОТРИЕНОЛЫ (ВИТАМИН Е) – 10 мг, ЛИПОЕВАЯ КИСЛОТА – 2,5 мг,
ЛИКОПИН – 1,5 мг + корень куркумы, плоды шиповника,..
2. «КОФЕРМЕНТ Q10 ПЛЮС»
- 10 мг
+ железо, магний, цинк, медь, плоды кайенского перца и боярышника –
улучшение кровотока, антиоксидантная активность
3. «ГРЭПАЙН с ПРОТЕКТОРАМИ»:
ГРЭПАЙН – протоантоцианиды из косточек винограда и сосновой коры – 20
мг, Экстракт из кожицы красного винограда – 50 мг,
Витамин С – 20 мг,
Томат – ликопин,
Цитрусовые биофлавоноиды +…
4. «ПЕРФЕКТ АЙЗ» :
комплекс антиоксидантов и мембранопротекторов
ВИТАМИН А – 1,8 мг, ВИТАМИН Е – 50 мг, ЛЮТЕИН – 3 мг, β-КАРОТИН – 6 мг,
ЭКСТРАКТ ЧЕРНИКИ – 100 мг, КВЕРЦИТИН – 5 мг, ГЛУТАТИОН – 12,5 мг,
СЕЛЕН – 25 мкг + цинк, медь, Витамины В2 и В6, Таурин – 100 мг
5. «ДИФЕНС МЭЙТЕНАНС»
- ЗАЩИТНАЯ ФОРМУЛА:
ВИТАМИН А – 1,5 мг, ВИТАМИН С – 120 мг, ВИТАМИН Е – 60 мг,
СЕЛЕН – 25 мг + …
6. «ВИТАМИН С» - 1000 мг
7. «ВИТАМИН Е» - 100 мг
8. «ЗАМБРОЗА»: Экстракт косточек и кожицы винограда,
черники, Экстракт зеленого чая, Экстракт облепихи +…
Экстракт
18.
БАД NSP – онкопрофилактика20
1. «Антиоксидант НСП» - антиоксиданты + куркума + ликопин +
токотриенолы + индол-3-карбинол
2. «Брест Комплекс» - глюкарат кальция + мэйтаке
3. «Буплерум Плюс» – трутовый гриб (пахимовая кислота)
4. «Кальций Магний Хелат» – источник кальция
5. «Коралловый Кальций» – источник кальция
6. «Хлорофилл Жидкий» - хлорофилл
7. «Перец Чеснок Петрушка» - петрушка
8. «Защитная Формула» – антиоксидант + индол-3-карбинол + лапахол
9. «Грэпайн с Протекторами» - антиоксидант + индол-3-карбинол +
куркума + томат + пикногенол
10. «Чеснок» – индол-3-карбинол + куркума
11. «Индол-3-карбинол» – индол-3-карбинол + сульфорафан
12. «Колострум» – шиитаке + мэйтаке
13. «Локло» – энтеросорбция + куркума
14. «Перфект Айз» - антиоксидант + витамин А + кверцетин
15. «По д’Арко» - лапахол + хлорофилл
16. «Суперкомплекс» - витамины и биоэлементы + индол-3-карбинол
+ куркума
17. «ТНТ» - витамины и биоэлементы
18. «Уро Лакс» - петрушка
19. «Витамин С» / «Витамин Е» – антиоксиданты


















 marketing
marketing medicine
medicine